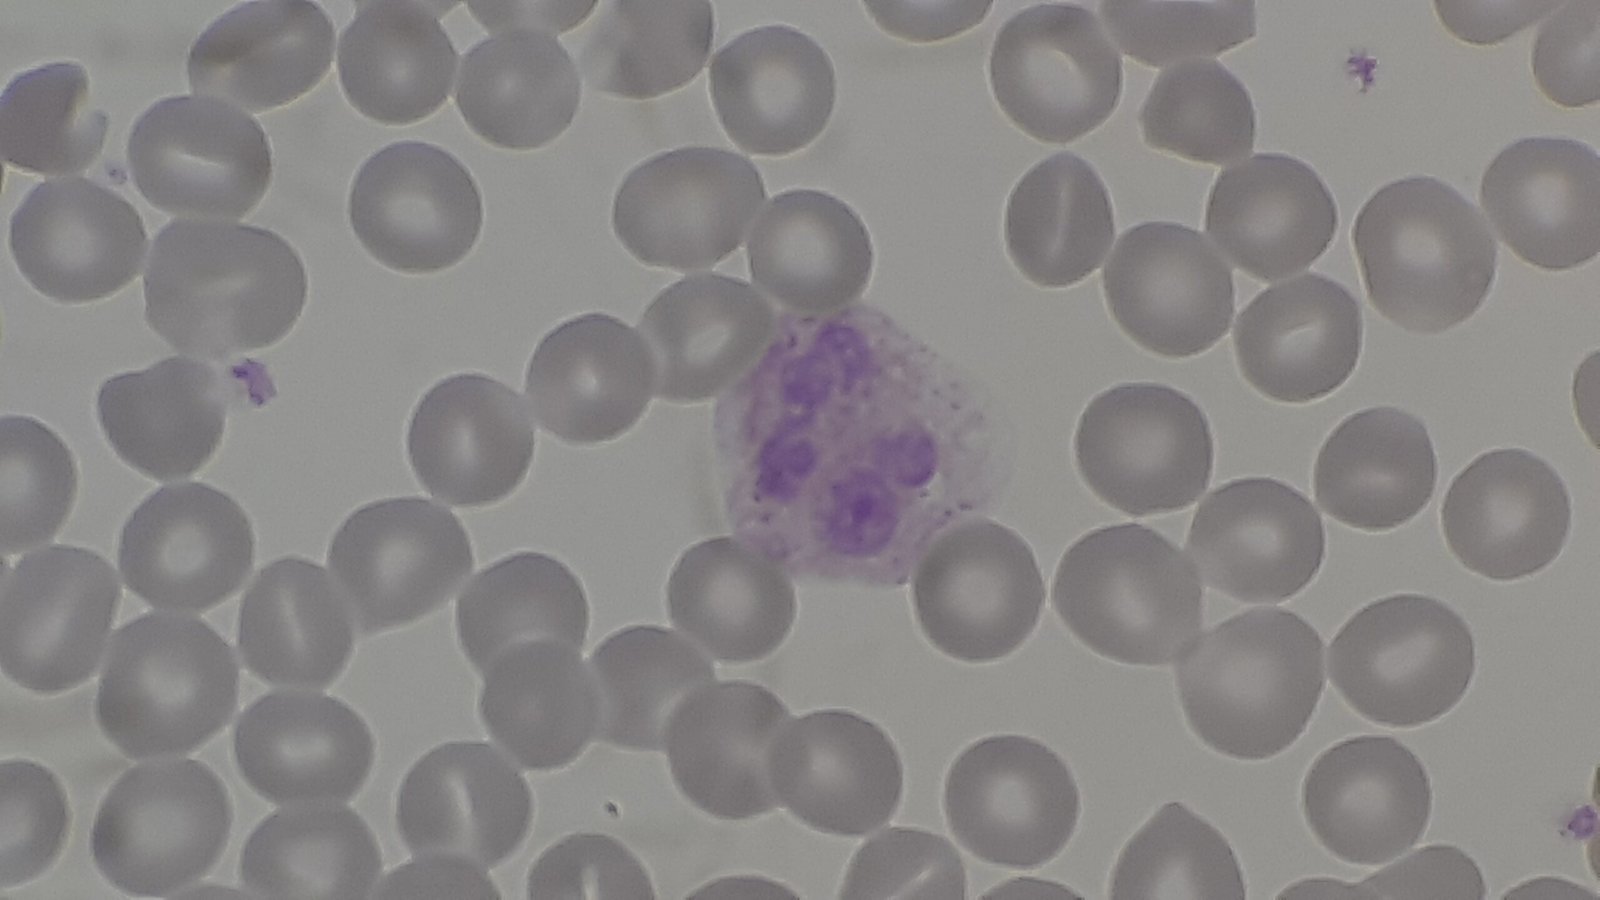
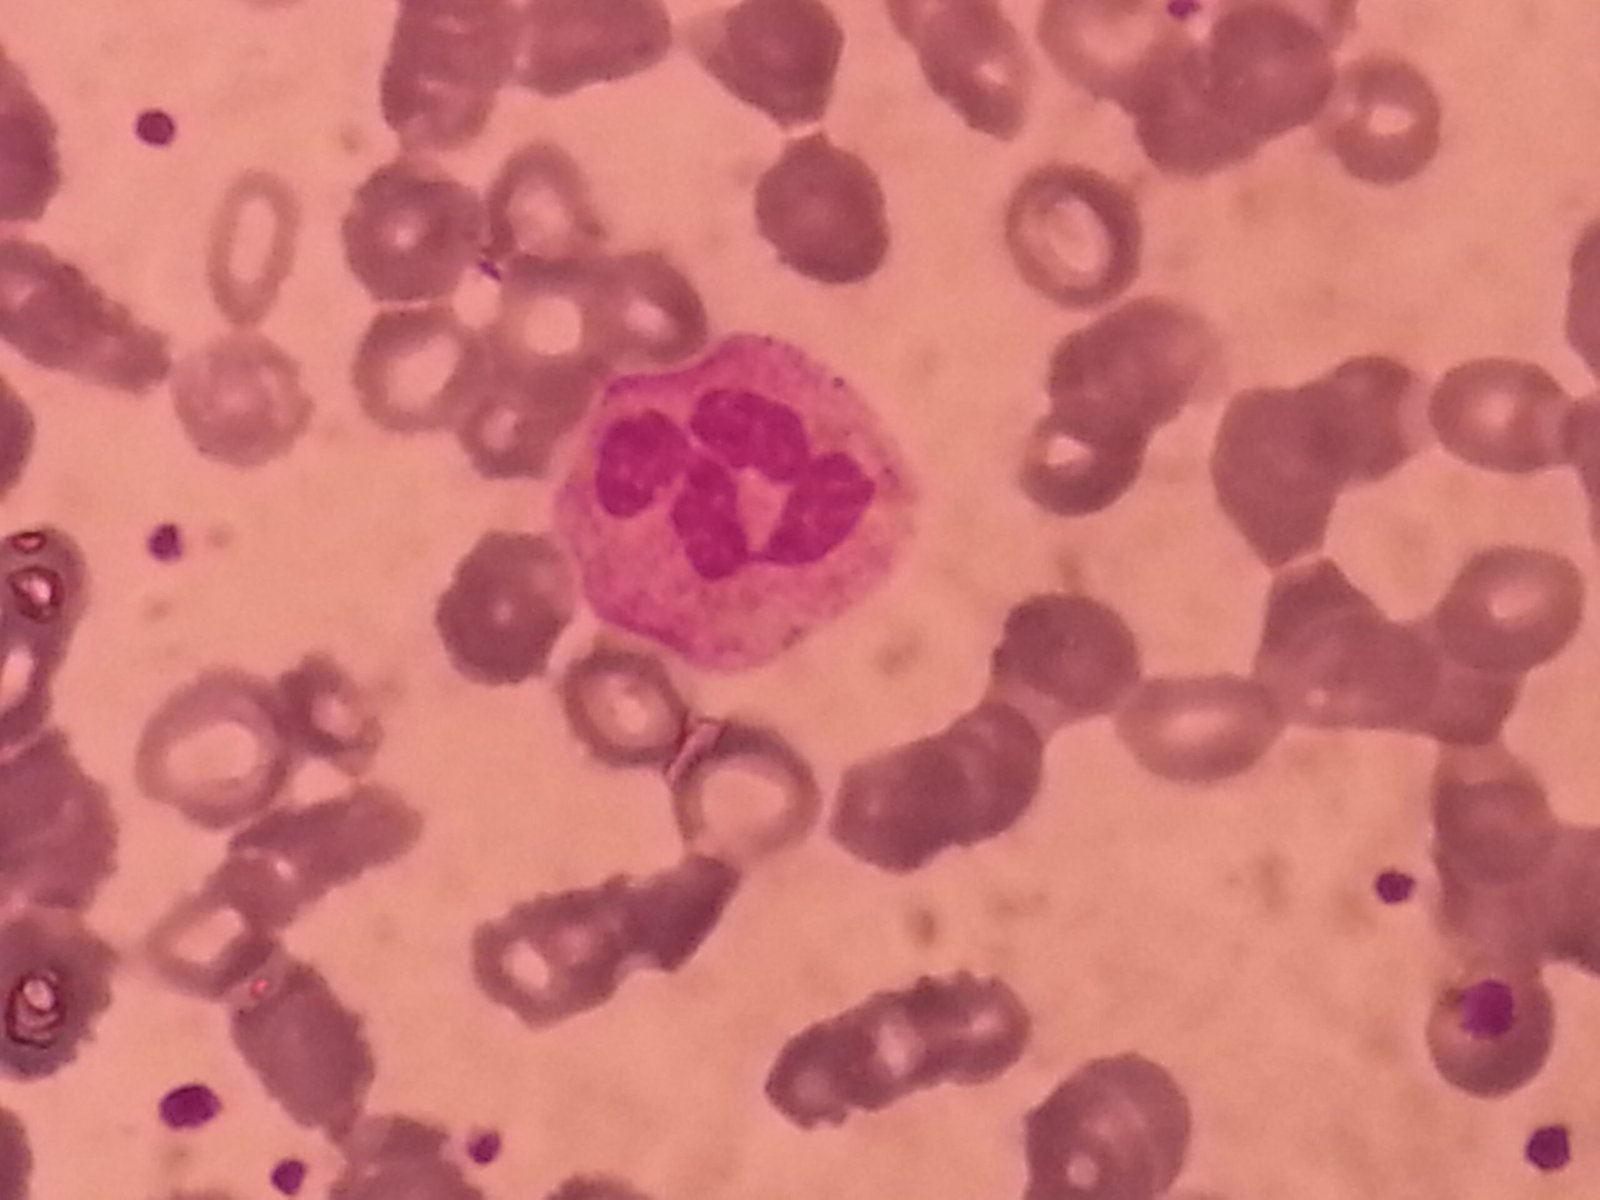

Imagine breezing through flu season while your friends are down for the count, or sitting next to a coughing coworker, untouched by the sniffles that sweep through your office every winter. It almost feels like magic—some people just don’t seem to get sick. Are they lucky, or is there something more mysterious at play? The truth is both fascinating and inspiring: hidden deep in our DNA, certain genetic secrets may grant a select few a kind of “super-resistance” to illness. As science peels back the layers of human immunity, we’re discovering why some people walk through viral storms unscathed—and what that could mean for all of us.
The Immune System: Nature’s Personal Bodyguard
The human immune system is a marvel of evolution, designed to patrol your body and strike down invaders like viruses and bacteria. Think of it as a well-trained army, always on alert, ready to deploy defenses at the first sign of trouble. But not all immune systems are created equal. Some people are born with immune responses that react faster, smarter, or stronger than most. These “super defenders” often breeze through outbreaks with barely a scratch. Their secret? It starts with genes passed down through generations, each tweak making their body a little better at fending off disease.
Genetic Mutations: The Hidden Power-Ups
Within our DNA, tiny differences can make a world of difference. Some genetic mutations act like power-ups, giving people enhanced resistance to particular diseases. For example, a mutation in the CCR5 gene famously protects some individuals from HIV infection. These lucky few inherited a genetic shield, while the rest of us remain vulnerable. It’s like being dealt a royal flush in the poker game of life—rare, but incredibly valuable. Scientists are still uncovering more of these genetic quirks, each one a new clue in the puzzle of super-resistance.
White Blood Cells: The Unsung Heroes
White blood cells—your body’s microscopic warriors—form the backbone of your immune system. Some people naturally produce more of these cells or have types that are unusually effective at recognizing and destroying pathogens. Imagine a security force where every guard is a black belt in karate. These supercharged defenders can spot trouble from a mile away and take it down before it spreads. Researchers have found that genetic differences influence not just the number, but the quality of these white blood cells, and that’s a big reason why some folks rarely get sick.
Inherited Immunity: The Family Advantage
If you’ve ever noticed that some families seem immune to the latest bug, you’re not imagining things. Inherited immunity is a real phenomenon, with certain families passing down immune-boosting genes. Think of it as a family recipe for resistance, honed over generations. For example, communities exposed to historical epidemics have sometimes evolved gene variants that help them fend off those same diseases today. This inherited armor can make the difference between falling ill and staying healthy, generation after generation.
Microbiome Marvels: The Gut Connection
Beneath the surface, trillions of microbes live in your gut, quietly shaping your health. The gut microbiome acts as a second immune system, training your body to recognize friends from foes. Some people are born with, or develop, especially diverse and balanced microbiomes, which can help them resist infections. It’s like having a garden that naturally repels weeds. Scientists now believe that a healthy, robust microbiome—often influenced by both genes and lifestyle—plays a big role in super-resistance.
Natural Killer Cells: The First Responders

Among the immune system’s many players, natural killer (NK) cells are the special forces. They’re the first to attack infected cells and stop viruses in their tracks. Some individuals have NK cells that are more active or efficient, thanks to genetic variations. Picture a fire brigade that always arrives before the flames get out of hand. Researchers have even identified families with unusually potent NK cell activity, offering them greater protection against everything from the common cold to more serious viral infections.
Blood Types: More Than Just Letters
Did you know your blood type could influence your susceptibility to certain illnesses? It’s true. For instance, people with type O blood have been shown in some studies to be less likely to contract severe malaria or certain strains of norovirus. The exact reasons aren’t fully understood, but it’s clear that blood type genes play a subtle yet important role in disease resistance. It’s like having a secret code that confuses some germs, keeping them at bay.
Genetic Memory: The Wisdom of the Ancestors

Your immune system never forgets a battle. Through a process called genetic memory, your body can “remember” past infections and respond faster the next time. Some people’s genetic makeup allows them to develop this memory more efficiently, giving them an edge against recurring illnesses. It’s a bit like a seasoned chess player who never falls for the same trick twice. Over time, these genetic advantages can mean fewer sick days and quicker recoveries.
Inflammation Control: The Delicate Balance
Inflammation is a double-edged sword: necessary for fighting infection, but dangerous if it gets out of control. Some people are genetically wired to keep inflammation in check, avoiding the damaging side effects that others might endure. Imagine a thermostat that never overheats, no matter how high the fever. This fine-tuned response can make the difference between a mild sniffle and a week in bed.
Autoimmunity and Super-Resistance: A Tricky Trade-Off
Interestingly, the same genes that grant super-resistance can sometimes backfire, leading to autoimmune diseases where the immune system attacks healthy tissue. It’s the price of having an overzealous bodyguard. Some people walk a tightrope, enjoying robust health most of the time but at risk for chronic conditions. It’s a reminder that genetic “gifts” often come with strings attached, and that balance is key to long-term health.
The Role of Epigenetics: Beyond the DNA Code
Not everything is set in stone at birth. Epigenetics—the study of how genes are turned on or off—shows that lifestyle, environment, and even stress can influence our genetic resistance to disease. People exposed to certain diets, clean environments, or mild infections early in life may develop stronger immune responses. It’s like learning to ride a bike: practice makes perfect, and sometimes the immune system needs a little training to become its best self.
Viral Gateways: How Cells Keep Invaders Out
Viruses need a way to enter your cells, and some people’s genetic makeup means their cells lack the necessary “doorways.” Without the right receptors, viruses like HIV or certain flu strains simply can’t get in. It’s like trying to break into a house when every window is locked tight. Scientists are exploring how these natural defenses can inspire new treatments and vaccines.
Historical Survivors: Lessons from the Past
History is full of devastating plagues and pandemics, yet some people always survived. Their genes often hold the key. For example, survivors of the Black Death passed on variants that still protect their descendants from related bacteria. It’s a living legacy, written in our DNA, that continues to shape who thrives and who falls ill when new diseases emerge. These genetic “time capsules” remind us that survival is often a matter of heredity as much as luck.
Global Diversity: Resistance Around the World
Genetic resistance isn’t evenly distributed. Different populations have evolved unique defenses based on the diseases they’ve faced. For instance, sickle cell trait—common in parts of Africa—offers protection against malaria. Meanwhile, certain Asian populations have evolved resistance to SARS-like viruses. These differences highlight the ingenuity of evolution and the way our genes adapt to local threats, painting a vivid picture of human diversity.
Environmental Influences: Not All Genes, All the Time
While genetics play a starring role, environment matters too. Clean air, safe water, good nutrition, and limited exposure to pathogens all help tip the scales toward health. A person with super-resistant genes might still fall ill in a polluted or stressful environment, while someone with average genetics can thrive with the right support. It’s a powerful reminder that nature and nurture are forever entwined.
Case Studies: Real-Life Super-Resisters
Every so often, scientists discover individuals who seem almost invincible—people who resist infection despite repeated exposure. One famous example is the so-called “Berlin patient,” who was cured of HIV after a bone marrow transplant from a donor with the CCR5 mutation. Other stories involve healthcare workers who never caught COVID-19, or children in malaria-endemic regions who never fall ill. These fascinating cases are more than medical curiosities—they’re guiding research toward bold new treatments for everyone.
Can We All Become Super-Resistant?
The dream of harnessing genetic resistance for everyone is closer than ever. Gene editing tools like CRISPR are already being used to mimic protective mutations in the lab. Vaccines, personalized medicine, and microbiome therapies are all inspired by what we learn from the naturally resistant. It’s not just about luck anymore; science is working to level the playing field, so that one day, more people might share in this remarkable advantage.
Everyday Habits: Boosting Your Own Defenses
While you can’t change your genes, you can still stack the odds in your favor. Regular exercise, a healthy diet, stress management, and good sleep are proven ways to support your immune system. Think of it as tuning up your internal engine—you might not become a superhuman, but you’ll be more resilient than you think. Even those with average genetics can enjoy above-average health with the right habits.
The Future of Super-Resistance: What Lies Ahead
As genetic research races forward, the line between super-resistant and ordinary may blur. With advances in medicine, the secrets of these rare individuals are being transformed into treatments and prevention strategies for the masses. The future could hold vaccines that offer the same protection as a lucky gene, or therapies that tweak your immune system to be smarter and faster. We’re on the brink of a health revolution, inspired by the rare few who almost never get sick.
Hope and Wonder: The Power of Human Resilience
The story of super-resistance isn’t just about rare genes—it’s a celebration of the human body’s endless adaptability. From ancient plagues to modern pandemics, our species has always found ways to survive and thrive. Whether you’re blessed with extraordinary genetics or simply doing your best with what you’ve got, there’s wonder in the fact that we all carry the legacy of countless survivors. Who knows what hidden strengths lie in your own DNA, waiting for their moment to shine?
